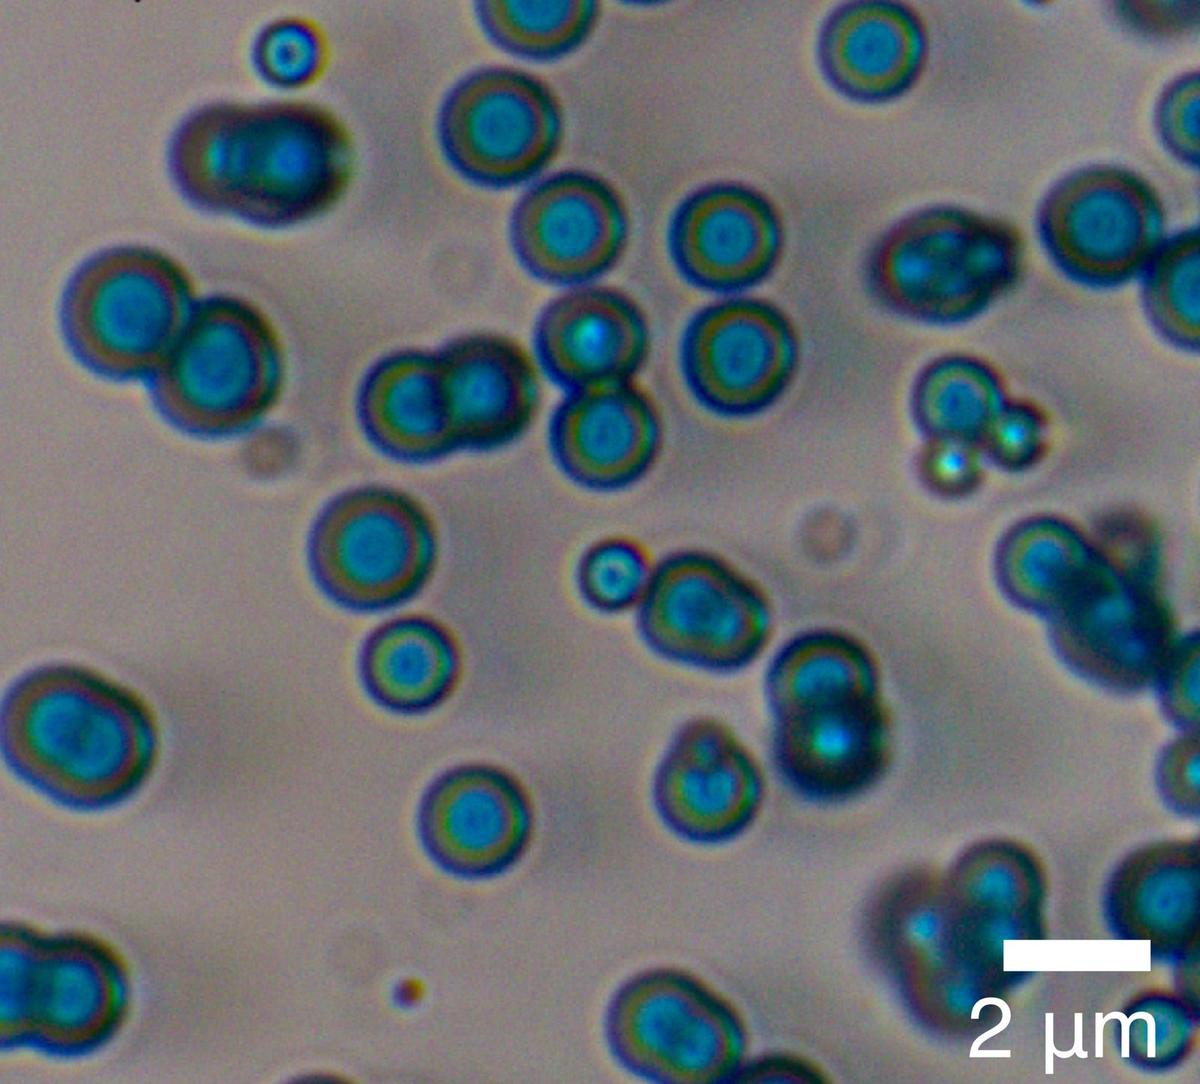
The blue spheres as seen through a microscope The blue spheres as seen through a microscope

It was early 2023. In a ground-floor laboratory at the National Centre for Biological Sciences (NCBS) in north Bengaluru, Ph.D candidate Nayan Chakraborty was readying to examine the results of another iteration of an experiment he had been attempting for three months. There was no reason to believe this trial, nearly his 1,000th, would be any different. But when he peered through the microscope, a shocked Chakraborty quickly texted his adviser: “Shashi, we have jeewanu in the lab!”
If Chakraborty was taken aback by what he saw, Shashi Thutupalli, who rushed to take a look, was visibly excited. There they were, those tiny blue spheres, just like the ones he had seen in images but was not expecting to see in his own lab. Thutupalli, an associate professor at Centre for Living Machines, NCBS-TIFR (Tata Institute of Fundamental Research) and ICTS-TIFR (International Centre for Theoretical Sciences), had chanced upon these spheres in the little-known but intriguing work of Krishna Bahadur and S. Ranganayaki, chemists, collaborators and life partners who worked at the University of Allahabad half a century ago.

Krishna Bahadur and S. Ranganayaki
Back in the 1960s, Bahadur had made an incredible claim: that by exposing a chemical mixture to sunlight for a period of time you get spheres that grow, multiply and show metabolic activity, and hence could be considered living units. So convinced was Bahadur that he named these jeewanu, meaning particles of life. The claim, and the work, did not go very far — for several reasons. Over the years, jeewanu, Bahadur and Ranganayaki faded into oblivion, kept alive mostly in the memories of close family and students.
Lessons in chemistry
That’s where it would likely have remained, if not for the curiosity and efforts of Thutupalli and Chakraborty. The successful attempt in 2023 was followed by three more years of work, the results of which are now out as a preprint (a version of a research paper available publicly before peer review).
In their paper, the duo reports that a mix of four simple compounds — formaldehyde, diammonium molybdate, ferrous sulfate and diammonium hydrogen phosphate — with molybdenum salts acting as a catalyst can self-organise into compartments that show growth, the possibility of multiplication and a rudimentary form of metabolism.
The new work, which involved the development of a minimal recipe, unlike Bahadur’s, and the use of modern techniques, does not claim that these structures, termed protocells — to be understood as a rudimentary, cell-like structure — are a living system, as Bahadur had. Instead, the findings, under peer review, are significant in other ways, from making deep connections to how life on Earth might have started to the possibility of questioning what we look for when we look for life elsewhere.
Shashi Thutupalli (left) and Nayan Chakraborty at the National Centre for Biological Sciences in Bengaluru.
| Photo Credit:
Sudhakara Jain
In the enduring question of how life originated on Earth, an explanation for the transition from non-biological processes to the living state, with extremely complex molecules, remains elusive despite innumerable efforts over the years. The new work tackles one step of this, offering a plausible explanation of how cell-like entities may have formed from a mix of simple compounds.
“You start with very simple stuff, and then you get a compartment that looks like a cell. That’s what makes it scientifically remarkable,” says Thutupalli, gesturing animatedly. “In the process, lipid-like and amino acid-like compounds are being made. So, you’re getting structural similarity and chemical similarity [to a cell], which is what makes this triply exciting.”
This, he says, was inspired by the approach Bahadur and Ranganayaki pioneered all those years ago. It was also a route he and his colleagues would never have explored, if Thutupalli had not stumbled upon jeewanu. Along the way, he ended up uncovering the story of an unconventional couple whom history had all but forgotten.
The blue spheres as seen through a microscope
A chance encounter
Thutupalli first came across the names of Bahadur and Ranganayaki in 2019 while reading the work of Hungarian chemist Tibor Ganti. Intrigued by Ganti’s reference to work he had never heard of, he tried to find out more. “I was very puzzled it was not better known because the magnitude of their claims makes it unmissable in a sense,” he says.
Bahadur, he went on to find, had published a paper in the international science journal Nature in 1954, describing his success with synthesising amino acids using sunlight as a source of energy. Coming soon after the famous Miller-Urey experiment where amino acids were produced from a gaseous mixture using electric discharge, the paper was noticed by important figures in the field. Among them was Soviet biochemist Alexander Oparin, who organised the first international symposium on the origin of life in 1957. Bahadur was one of only two Indians invited, though he eventually did not attend because he did not get a visa. The following year, he had another paper out in Nature, on fixing atmospheric nitrogen to make amino acids, using molybdenum as a catalyst.


“I feel like this is a constant problem in the sciences, that if you happen to belong to certain advanced nations and come from well-ranked institutes in that part of the world, your research is taken more seriously.”Sudha RajamaniProfessor, IISER Pune
Then, in the early 60s came his bold claim about getting jeewanu, from a mixture of formaldehyde and a few inorganic salts, particles which he said were compartments, displayed metabolism, growth and reproduction by budding (a type of asexual reproduction) and hence were “living”. It did not seem to have received wide attention, but met with some strong criticism. A 1967 review by two NASA scientists questioned the sterility of the mixtures and concluded that insufficient evidence was offered to prove the claims. Thutupalli could find little mention of the jeewanu work after this.
But he was struck by two things: one, that Bahadur and Ranganayaki had been able to get spheres from a mix of salts, which normally yields only crystals. He also felt that the contamination criticism was unconvincing since one of the ingredients was formaldehyde, typically used to preserve specimens. He discussed his findings with Chakraborty.
Unknown to Thutupalli, Chakraborty, a chemist by training, began spending his evenings and weekends trying out different permutations and combinations of the ingredients. “Even now, Shashi talks about how he had no idea I was doing this for three-four months,” Chakraborty says with a grin.

“The fact that similar structures were found in the ocean suggests there are spots on earth where this kind of chemistry might be facilitated. It’s certainly worthy of more investigation.”Shashi ThutupalliAssociate professor, Centre for Living Machines, NCBS-TIFR
While the lab work progressed, Thutupalli decided to find out more about the personalities behind jeewanu, casting his net wide in the research community. Finally, he found a number for an Ila Bahadur, who turned out to be Bahadur and Ranganayaki’s daughter. “I was so excited, I started talking very fast,” Thutupalli chuckles at the memory of that first conversation. The couple’s four children, it turned out, had preserved as much of their parents’ work as they could. It was not just out of respect for their memory — presciently, their mother had told them that while their work did not get the recognition it deserved, someone might come along later, asking about their research papers.
The records, books and letters, now part of the archives at NCBS, also reveal the extent of the ignominy Bahadur had to endure, indicating at least one possible reason for the muted response to his and Ranganayaki’s work.
Against all odds

Krishna Bahadur and S. Ranganayaki with their children.
| Photo Credit:
Courtesy NCBS
Bahadur and Ranganayaki, Ila recounts, met at the University of Allahabad, where they were both students of N.R. Dhar, the well-known professor of chemistry. Ranganayaki, who was from Chidambaram in Tamil Nadu, married Bahadur against her parents’ wishes. The couple collaborated in their research, starting with amino acid synthesis and publishing papers together. So involved were they in their work that when Ranganayaki was hospitalised for a fortnight, their students set up the experiment in a ward with sunlight so that they could keep going.
“For us, it was not unusual — this was part of life,” says Ila. The first paper on jeewanu was published before she was born. But as she got older, she became conscious of the shadow cast by the criticism of her parents’ work. “My mother was more vocal about her anger over people not accepting their work. My father used to keep quiet, but he was sad,” she says.
In his 2011 paper ‘Jeewanu, or the ‘particles of life’’, Mathias Grote, a historian of science who examined the work from a historical perspective, discusses the reception to jeewanu. He writes that Hungarian scientist Ganti’s explanation of why the scientific community was either ignorant or dismissive of Bahadur’s work was explicit: “Bahadur and his co-workers believe that Jeewanus live… However, the scientific world believes that they are inanimate artefacts and it does not even consider the results, let alone tries to disprove them… The belief of the scientific world is based on prejudice. It is prejudice, first against the unusual, unexpected, and strange experimental results, and second against the modest, too simple, and hardly equipped experimental methods.”

“The biggest achievement will be other scientists picking up this work — because science is a social, collaborative process.”Nayan ChakrabortyResearch scholar, National Centre for Biological Sciences
Grote himself writes that whether one considers it a drawback or a virtue, Bahadur did not stick to the work style of his time. He used technically simple equipment, “varying the protocols frequently and documenting them somewhat idiosyncratically”. The fact that the four main papers on jeewanu appeared in a little-known German journal may also have limited its reach. Then there was the 1967 review of the work co-authored by Sri Lankan biochemist Cyril Ponnamperuma, a leading figure at NASA’s exobiology division at the time. The review said the experimental procedures were presented in a confusing manner, questioned the sterility of the mixtures, and concluded that the “nature and properties of the jeewanu remains to be clarified”. This critique, writes Grote, “was fierce and probably influential”.
Bahadur’s correspondence, now public for the first time, reveals more. His papers in Nature had attracted the attention of Sidney W. Fox, a prominent biochemist in the U.S. Bahadur accepts the invitation to work in his lab but then the two fall out and Bahadur returns to India. Fox insists that the experiment results cannot be repeated, based on his students’ attempts. But he does not stop there. In a response addressed to Bahadur in 1963 but also sent to several others, he writes: “… a hurried and careless treatment of a subject of such importance is potentially a crime against all humanity”, going on to add, “Our considered judgement here is that you have deceived yourself in your own observations.” He ends the letter by writing: “I regret indeed that you have so allowed yourself to be blinded to reality.” Among the recipients of the communication was NASA’s Ponnamperuma.
While it’s hard to state with certainty why Bahadur’s work was not received favourably, Thutupalli says it does seem reasonable and likely that the criticism of these important scientists would have played a big role. There’s also the fact that extraordinary claims require extraordinary evidence. “They did what they could but that was not enough,” he says. For example, while Bahadur claimed the formation of lipids, the NCBS researchers mention lipid-like molecules in their paper, not lipids, because the latter would require more chemical analysis.
But while some of Bahadur’s claims have not been replicable, Thutupalli and Chakraborti show that many were correct, and it was inaccurate to say the jeewanu experiment as a whole was not reproducible. “Even if the criticism was that the evidence for the claims was insufficient, that was only grounds for further investigation, not for the complete dismissal of the research programme,” says Thutupalli. That’s what typically happens with research: “You try a little more, you take the next step, you get a little more evidence.” In the case of Bahadur and Ranganyaki’s work, though, it was cut off right at the start — for some or all of the reasons outlined earlier.

An archival photo of S. Ranganayaki and Krishna Bahadur.
| Photo Credit:
Courtesy NCBS
What lies ahead?
Both Thutupalli and Chakraborty hope that once their paper is peer reviewed, more researchers will build on it. “The biggest achievement will be other scientists picking up this work — because science is a social, collaborative process,” says Chakraborty. “It will be much more reproducible and rigorous when groups around the world do it.”
Philippe Nghe, a professor at the Ecole Polytechnique’s Structural Biology of the Cell Laboratory in France, who’s exploring the role of RNA in the origin of life, says the fact that their work combines two elements that are essential for the emergence of life makes it interesting. “The study proposes a plausible route by which simple chemical mixtures, under generic conditions, could generate both catalytic chemistry and compartmentalisation — key ingredients required for chemical systems to eventually undergo selection and evolution,” he says.
According to Sudha Rajamani, professor of biology at IISER Pune, the work opens up potentially new possibilities in thinking about how these jeewanu-like entities could have also played a role in early processes that set the stage for the transition from chemistry to biology on the early Earth. Like many others, Rajamani was unaware of Bahadur’s research, hearing of it only a decade ago. “I feel like this is a constant problem in the sciences, that if you happen to belong to certain advanced nations and come from well-ranked institutes in that part of the world, your research is taken more seriously,” she says.
Some, though, are sceptical. Discussing the work of Bahadur and some of his peers, Henderson Cleaves, professor and chair, department of chemistry, Howard University, who tried years ago to reproduce Bahadur’s work with what he terms mixed results (it yielded microscopic structures but not specific molecules) says it appears easy to mix some chemicals in a test tube, look at the results, see that there are small cell-like structures and then claim you have made life in a test tube. The fact that there is “no good working definition of life” makes it extremely hard to prove that whatever these scientists find fits it, he says.
In his view, the history of scientists like Bahadur involved a great deal of “seeing what you want to see”. He adds that while he is happy someone else is re-examining Bahadur’s experiments, he thinks the new work is falling into the same “cognitive traps”. In response, Thutupalli emphasises that they are certainly not claiming to have synthesised life in the lab. “The data we present is unambiguous in showing that compartments and complexifying chemistry self-organise from very simple initial conditions,” he says.
Interestingly, in July 2024, a paper by marine biologists reported the discovery of blue spheres within sponges in the ocean. The NCBS researchers found that the structures they made in the lab and those discovered in the ocean shared similarities in atomic composition — both have an abundant amount of molybdenum and significant amounts of carbon, oxygen and phosphorus. “The fact that similar structures were found in the ocean suggests there are spots on earth where this kind of chemistry might be facilitated. It’s certainly worthy of more investigation,” says Thutupalli.
Their work, he adds, could also inform the way we search for life elsewhere in the universe. “Could the kind of compartments we found be a different kind of life-like organisation that we don’t classify according to our current definition? These are all questions it opens up.”
After her first conversation with Thutupalli, Ila says she was so excited she called up everyone she could think of. “We used to feel so bad that our parents’ work was just dying and there was nothing we or anyone else could do,” she says. She’s now hopeful their contribution may finally be acknowledged and put to some use. “I’m just really keen to see what will be next.”
The writer is a Bengaluru-based independent journalist.




